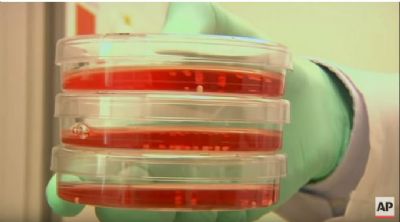

Fussball-Trikots aus den
60er und 70er Jahren. Kult und Style pur!

|
|

schatzsuche.ch
Gratis-Wettbewerb
Flugreise für 2 Personen
& 100 Tagespreise zu gewinnen!
Spielspass pur!
|
|
|
|
Diese Mini-Hirnteile sollen bei der Erforschung von Autismus und Schizophrenie Fortschritte bringen.
|

Montag, 9. November 2015 / 09:53:22
Forscher züchtet lebende Mini-Hirnteile im Labor

Stanford - In seinem Labor an der kalifornischen Stanford University hat der Neurowissenschaftler Sergiu Pasca wesentliche Bestandteile eines lebendigen Gehirns erstmals künstlich nachgezüchtet.
|

| 
|
Publireportage

Mit dem Privatjet durch Europa

Nach Cannes, Nizza, Paris, Amsterdam, Düsseldorf oder London jetten? Von einem zentral in Europa gelegenen Flughafen wie dem von St. Gallen und Altenrhein in der Schweiz ist das überhaupt kein Problem.
[ weiter ]
|
|